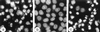

Competing death programs in poliovirus-infected cells: commitment switch in the middle of the infectious cycle
- PMID: 10823859
- PMCID: PMC112039
- DOI: 10.1128/jvi.74.12.5534-5541.2000
Competing death programs in poliovirus-infected cells: commitment switch in the middle of the infectious cycle
Abstract
Productive poliovirus infection of HeLa cells leads to the canonical cytopathic effect (CPE), whereas certain types of abortive infection result in apoptosis. To define the time course of commitment to the different types of poliovirus-induced death, inhibitors of viral replication (guanidine HCl) or translation (cycloheximide) were added at different times postinfection (p.i.). Early in the infection (during the first approximately 2 h p.i.), predominantly proapoptotic viral function was expressed, rendering the cells committed to apoptosis, which developed several hours after viral expression was arrested. In the middle of infection, concomitantly with the onset of fast generation of viral progeny, the implementation of the viral apoptotic program was abruptly interrupted. In particular, activation of an Asp-Glu-Val-Asp (DEVD)-specific caspase(s) occurring in the apoptosis-committed cells was prevented by the ongoing productive infection. Simultaneously, the cells retaining normal or nearly normal morphology became committed to CPE, which eventually developed regardless of whether or not further viral expression was allowed to proceed. The implementation of the poliovirus-induced apoptotic program was suppressed in HeLa cells overexpressing the Bcl-2 protein, indicating that the fate of poliovirus-infected cells depends on the balance of host and viral pro- and antiapoptotic factors.
Figures

References
-
- Agol V I, Belov G A, Bienz K, Egger D, Kolesnikova M S, Raikhlin N T, Romanova L I, Smirnova E A, Tolskaya E A. Two types of death of poliovirus-infected cells: caspase involvement in the apoptosis but not cytopathic effect. Virology. 1998;252:343–353. - PubMed
-
- Bienz K, Egger D, Rasser Y, Bossart W. Kinetics and location of poliovirus macromolecular synthesis in correlation to virus-induced cytopathology. Virology. 1980;100:390–399. - PubMed
-
- Bienz K, Egger D, Rasser Y, Bossart W. Intracellular distribution of poliovirus proteins and the induction of virus-specific cytoplasmic structures. Virology. 1983;131:39–48. - PubMed
Publication types
MeSH terms
Substances
LinkOut - more resources
Full Text Sources
Research Materials
Miscellaneous